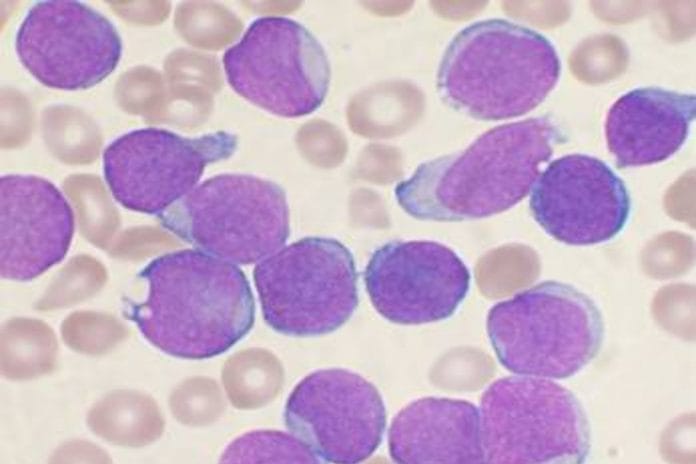
A Wright's stained bone marrow aspirate smear from a patient with B-cell acute lymphoblastic leukemia | Commons

Bengaluru: Two groups of US researchers have in separate papers reported promising results from the Phase 1 trial of a drug for advanced and treatment-resistant leukaemia.
The new drug, known as revumenib, was tested on 60 patients with an acute form of the disease, and over half experienced complete or partial remission. More than three-quarters of the latter group were still in recovery two months after remission.
The findings from this Phase 1 trial — conducted across nine sites in the US between 2019 and 2022 with a limited number of volunteers — show early evidence of potential treatments for acute leukaemia.
They were published in the journal Nature Wednesday as part of a study conducted by Ghayas Issa of the University of Texas MD Anderson Cancer Center in Houston, and his colleagues.
In a related Phase 1 study, also published in Nature the same day, researchers including Scott Armstrong of the Dana-Farber Cancer Institute in Boston, investigated specific mutations in identified genes that could result in resistance to revumenib.
Understanding these “treatment-escape” routes would provide valuable information to combat drug-resistant treatments, such as the ones for leukaemia too.
Leukaemia is a cancer of the blood, originating in the bone marrow, where red blood cells are produced. There are acute and chronic leukaemia types, and all types combined accounted for nearly 4 per cent of global cancer deaths in 2020.
The survival rate for acute and drug-resistant leukaemia is quite poor, sometimes as low as 8 per cent.
Also Read: India accounts for 1 in every 5 cervical cancer cases, almost 1 in 4 deaths, finds Lancet study
Menin, and revumenib’s role as menin inhibitor
The genes in the human body responsible for acute leukaemia have been well studied and established. These genes undergo sets of typical mutations as the disease develops, which has also been documented.
Acute leukaemia is characterised typically by either a mutation on the NPM1 gene or a rearrangement of the KMT2Ar gene. Both these genes have been shown to play a role in the progression of the disease.
There aren’t any existing treatments that target these genes. Early, pre-clinical studies have shown that menin, a protein that is responsible for suppressing tumours, enables the progression of mutations in the two leukaemia genes.
This indicates that menin plays a key role in facilitating the cancer, suggesting that menin inhibition could reverse or stop cancer progression.
Revumenib, whose efficacy and safety the two Phase 1 studies are testing, is believed to be a potent, oral, selective inhibitor of menin.
Remission with revumenib
According to the first study conducted by Issa and colleagues, 68 patients were treated with an experimental dose of revumenib, formerly known as SNDX-5613. They included 60 adults and 8 people under the age of 18 — the first ever humans to be treated with this drug.
Of the 68, 60 qualified for evaluation. At least 53 per cent of these 60 participants experienced some degree of remission or stop in growth of cancer, with 30 per cent (18 of the 60) experiencing complete remission.
Of these 18, 78 per cent had no measurable residual disease after only two months.
“We found an encouraging clinical benefit, with deep molecular remissions and minimal toxicities, in a heavily pretreated population of both children and adults with advanced acute leukaemia,” wrote the authors of the paper.
While the results are promising, they are not without side-effects. Over three-quarters of the participants experienced at least one adverse event such as irregular heartbeat, nausea, or vomiting.
But their recovery provides strong ground for a future Phase 1 study involving more people, using a different formula for the drug, and testing for efficacy.
Combating drug resistance
In the second analysis of the data, Armstrong and colleagues studied some mutations that make genes exhibit selective resistance to menin inhibition and drugs like revumenib.
They identified mutations in the MEN1 gene, which encodes menin. These mutations were detected in many patients who initially responded to the drug, but stopped after some time.
The researchers found that the mutations could result in resistance to menin inhibition through changes at the drug-binding site, resulting in individuals becoming treatment-resistant.
“To our knowledge, this study is the first to demonstrate that a chromatin-targeting therapeutic drug exerts sufficient selection pressure in patients to drive the evolution of escape mutants that lead to sustained chromatin occupancy, suggesting a common mechanism of therapeutic resistance,” wrote the authors.
Identifying such pathways which lead to drug resistance is important to understand various ways to not only combat drug resistance for treatment-resistant diseases, but also to improve the formula of existing drugs for better efficacy.
(Edited by Gitanjali Das)
Also Read: Gender skew in cancer diagnosis? Just 1 in 3 child patients in Delhi & 2 of 5 in Chennai are girls